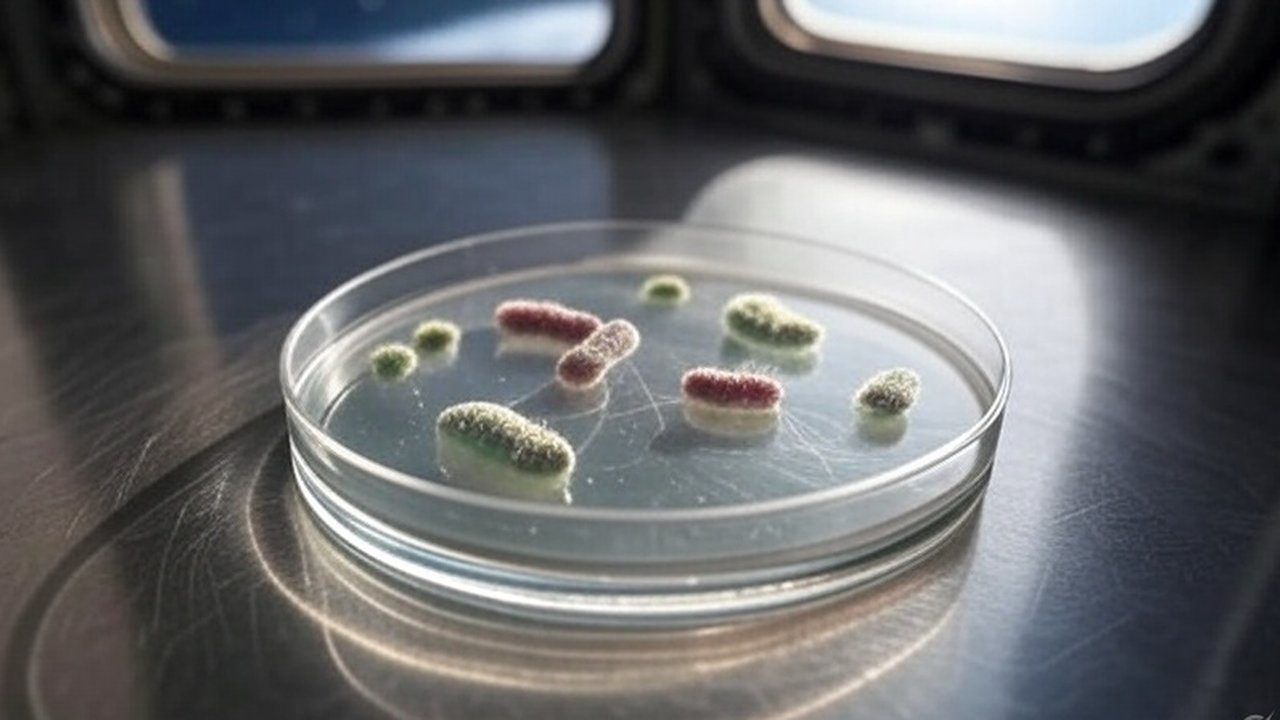
Ada Spesies Bakteri Baru yang Ditemukan di Stasiun Luar Angkasa China

Ada Spesies Bakteri Baru yang Ditemukan di Stasiun Luar Angkasa China
Bakteri itu pertama kali ditemukan oleh taikonaut asal China di permukaan perangkat keras stasiun antariksa pada bulan Mei 2023.
Penemuan spesies bakteri baru terjadi di stasiun luar angkasa Tiangong milik China. Bakteri dengan strain Niallia ini dianggap memiliki potensi unik yang dapat mendukung misi luar angkasa di masa depan.
Seperti yang dikutip dari laman Sky News pada Sabtu (24/5), penelitian ini telah dipublikasikan dalam jurnal internasional, Journal of Systematic and Evolutionary Microbiology.
Penelitian ini sangat penting untuk menjaga kesehatan para astronaut serta memastikan fungsi optimal pesawat luar angkasa. Mikroorganisme dapat berpengaruh pada sistem pendukung kehidupan dan material pesawat, yang berpotensi menyebabkan korosi atau degradasi.
Oleh karena itu, studi mengenai bakteri yang dapat bertahan hidup di luar angkasa juga diperlukan untuk memahami cara mencegah dan mengendalikan kontaminasi di dalam pesawat.
Bakteri ini pertama kali ditemukan oleh astronaut China, atau taikonaut, pada permukaan perangkat keras stasiun antariksa pada Mei 2023. Proses isolasi dan identifikasi bakteri dilakukan dengan menggunakan metode sekuensing genetik.
Hasil studi menunjukkan bahwa strain ini merupakan jenis baru dari genus Niallia. Sebelumnya, bakteri ini telah dikenal mampu bertahan hidup di lingkungan ekstrem di Bumi.
Selanjutnya, bakteri ini dianalisis untuk memahami cara bertahan dalam kondisi yang sulit. Lingkungan luar angkasa menghadirkan berbagai tantangan bagi makhluk hidup, termasuk gravitasi mikro, radiasi kosmik, tekanan rendah, serta keterbatasan oksigen dan nutrisi.
Batasi Paparan Radiasi
Menurut laporan yang ada, strain baru ini mungkin memiliki ketahanan yang lebih baik terhadap radiasi dan stres oksidatif. Selain itu, bakteri ini menunjukkan kemampuan unik dalam menghidrolisis atau memecah gelatin, yang bisa sangat berguna di lingkungan dengan ketersediaan nutrisi yang terbatas.
Hasil penelitian juga mengungkapkan bahwa strain ini dapat membentuk biofilm, yaitu lapisan pelindung tipis yang memungkinkan koloni bakteri bertahan lebih lama pada permukaan benda. Memahami kemampuan ini sangat penting karena dapat memengaruhi kesehatan kru serta operasional misi yang berlangsung dalam jangka waktu panjang.
Penemuan ini membuka peluang baru dalam pemanfaatan mikroorganisme untuk mendukung keberlangsungan hidup manusia dalam misi luar angkasa yang panjang, termasuk misi ke bulan atau Mars.

























:strip_icc():format(webp)/kly-media-production/medias/8257087/original/076336600_1781198103-140138.jpg)
:strip_icc():format(webp)/kly-media-production/medias/5557147/original/077231400_1776320306-IMG_4707.jpeg)
:strip_icc():format(webp)/kly-media-production/medias/8257072/original/066857000_1781192564-36745.jpg)
:strip_icc():format(webp)/kly-media-production/medias/8257053/original/055777100_1781190006-1001439827.jpg)
:strip_icc():format(webp)/kly-media-production/medias/8256906/original/046879200_1781175775-IMG_5827.jpeg)
:strip_icc():format(webp)/kly-media-production/medias/8257009/original/077584100_1781183698-ab6efb61-b114-4b82-8c89-46a037450f98.jpg)

















